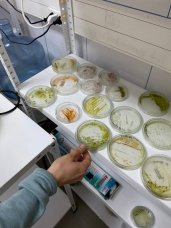
Biotecnología Celular y Molecular

NUESTRO MAGISTER
El Magíster en Biotecnología está dirigido a profesionales y/o investigadores de las áreas de ciencias biológicas, agropecuarias y biotecnología que quieran profundizar sus conocimientos teóricos y prácticos en la disciplina de biotecnología con énfasis en los recursos naturales renovables.







OBJETIVO GENERAL
“Formar postgraduados/as con sólida formación en el área de la biotecnología, que contribuyan al desarrollo de la investigación científica y/o aplicada orientada a generar productos, procesos y servicios innovadores para el sector privado y público a nivel regional y nacional”.
OBJETIVOS ESPECÍFICOS
- Desarrollar investigación básica y/o aplicada en el área de las ciencias biológicas que aporte a la generación de conocimiento y aplicaciones biotecnológicas sustentables para el mejoramiento de la productividad en instituciones privadas y/o públicas de la región de Tarapacá y de la Macrozona norte.
- Promover el pensamiento reflexivo y analítico que facilite abordar de manera independiente, creativa e innovadora los desafíos de la investigación en biotecnología y del ejercicio profesional en los sectores público y privado de la región de Tarapacá y la Macrozona Norte, integrando principios de sustentabilidad para contribuir al desarrollo sostenible de la región.

PERFIL DE EGRESO
Los estudiantes podrán adquirir las siguientes competencias:
- Desarrollar investigación aplicada en el área de la biotecnología para proponer soluciones prácticas y creativas a los problemas que detecta en el contexto académico y productivo nacional, con énfasis en la Macrozona Norte.
- Innova en el diseño, implementación y ejecución de herramientas y procesos en el área de la biotecnología y bioproducción para la gestión sustentable de los recursos naturales renovables.
- Diseña proyectos biotecnológicos que contribuyan al desarrollo científico-tecnológico del sector público y/o privado nacional y de la Macrozona norte.
- Participa de equipos de trabajo interdisciplinares para el desarrollo de nuevos productos y procesos biotecnológicos, resguardando aspectos éticos y de respeto, de acuerdo con los requerimientos del contexto público y privado nacional y regional.
INFORMACIÓN DE CONTACTO
LÍNEAS DE INVESTIGACIÓN
Las líneas de investigación que sustentan el programa corresponden a:
Biotecnología Celular y Molecular
Línea dedicada a investigar los mecanismos celulares y moleculares de los organismos biológicos, con un enfoque especial en ambientes desérticos y extremos de la Macrozona Norte de Chile. Su objetivo es comprender los procesos biológicos fundamentales y desarrollar herramientas biotecnológicas innovadoras para impulsar la creación de bioproductos, diagnósticos, terapias y mejoras en procesos clave para la industria, la salud y el sector agropecuario.
Tecnologías de Bioproducción
Diseño y desarrollo de procesos biotecnológicos sustentables para la generación de bienes y/o servicios innovadores dirigidos para el sector industrial, agropecuario y de salud.

PLAN DE ESTUDIOS
Actividades curriculares fundamentales
- Herramientas Biotecnológicas: La actividad curricular está diseñada para proporcionar a los/as estudiantes del Magíster en Biotecnología una formación avanzada y actualizada en las tecnologías biotecnológicas más relevantes y ampliamente utilizadas en investigación básica y aplicada. Dada la rapidez con la que evolucionan estas herramientas, la asignatura se centra en brindar un conocimiento integral y práctico sobre las técnicas más innovadoras que están transformando el panorama científico y tecnológico en las áreas biomédica, agronómica e industrial.
- Tecnologías de Bioproducción: La asignatura abordará las principales herramientas biotecnológicas, así como sus estrategias para mejorar la producción microbiológica, vegetal y acuícola. Lo cual, permitirá obtener beneficios en relación con nuevos y/o mejorados bioproductos y servicios.
- Innovación y Emprendimiento en Biotecnología: Esta actividad curricular, de naturaleza teórico-práctica, se encuentra orientada a que los/las estudiantes del Magíster en Biotecnología incorporen los conocimientos, habilidades y destrezas requeridas para el diseño de proyectos que fomenten la innovación y el emprendimiento en la formulación de productos y/o procesos biotecnológicos.
Actividades curriculares electivas
- Metabolómica vegetal.
- Aplicaciones biotecnológicas para la gran altura.
- Bioinformática aplicada a la biotecnología.
- Tópicos en sensores y biosensores para analitos de interés biológico.
- Biosíntesis de nanomateriales y sus aplicaciones biotecnológicas.
- Sistemas de producción biointegrados.
- Diseño y evaluación de fotobiorreactores.
- Aplicaciones biotecnológicas asociados a estrés hídrico en cultivos y especies agroforestales.
70 créditos totales (I y II semestre: 15 créditos, respectivamente; III y IV: 20 créditos, respectivamente.)
Duración: 4 Semestres

Grado académico de Licenciado Ciencias Biológicas, Ciencias del Mar, Ingeniería en Biotecnología y Ciencias Agronómicas. Asimismo, podrán postular titulados en alguna disciplina afín con duración equivalente a una licenciatura.
- Certificados Titulo/licenciatura
- Certificado de concentración de notas
- Curriculum vitae completo (formato PDF)
- Documento de identidad o pasaporte
- Carta de motivación y/o interés de ingreso donde específique su área de investigación o de desarrollo
- Dos cartas de referencias
Fechas importantes
Inicio postulación: Noviembre 2024 hasta enero 2025.
Inicio clases: Abril 2025.
Pasos del Proceso
Los/as postulantes, deberán ingresar al sistema online de la Universidad (Módulo de Prematricula) donde deberán hacer su postulación formal adjuntando la documentación que se requiera (Artículo 19 del Reglamento Interno).
El Comité Académico del Programa presidido por su directora/a, revisarán y evaluarán los antecedentes de los/as postulantes en base a la “Pauta de Evaluación de los Antecedentes de Postulación”.
En el caso de ser preseleccionado, el comité citará al/la postulante a una entrevista, la que podrá ser presencial o virtual según protocolo establecido y definido por el programa para tal efecto. El objetivo es conocer en mayor detalle los intereses académicos y profesionales del/la postulante, expectativas del programa, constatar la información proporcionada por estos/as y evaluar su capacidad de comprensión de la literatura científica por medio del análisis de un artículo científico y su relato.
Se revisarán entonces todos los antecedentes y entrevista de los/las postulantes preseleccionados en base a la “Pauta de Evaluación de Antecedentes de Postulación”. Posterior a ello, el/ la director/a del programa les informará por medio de correo electrónico notificando la aceptación o no aceptación del ingreso al programa.
Arancel programa : $ 5.557.020
Arancel de matrícula : $146.000
Programa acreditado por 3 años. Desde octubre 2022 hasta octubre 2025.
Criterios de selección
Pauta de evaluación de antecedentes de postulación:
Postule desde AQUÍ
|
Aspectos a evaluar |
Puntaje |
Escala |
|
Motivación para con el programa (autoevaluación) |
- |
Alta: 20 Media: 10 Baja: 5 Nula: 0
|
|
Motivos de la elección del programa (autoevaluación) |
- |
|
|
Disponibilidad de tiempo y disposición para con las exigencias del programa (autoevaluación) |
- |
|
|
Capacidad de trabajo en grupo (autoevaluación) |
- |
|
|
Capacidad de trabajo en autónomo (autoevaluación) |
- |
|
|
Capacidad de liderazgo del postulante (autoevaluación) |
- |
|
|
Capacidad de iniciativa (autoevaluación) |
- |
|
|
Capacidad de identificar fortalezas y debilidades del postulante (autoevaluación) |
- |
|
|
Aporte del programa al desarrollo profesional del postulante. |
- |
Alta: 20 Media: 10 Baja: 5 Nula: 0 |
FECHA DE INICIO DEL PLAN
Comienzo de las clases: abril 2025
LUGAR DONDE SE IMPARTIRÁ EL PROGRAMA
Iquique - Casa Central
DOCUMENTOS
![]() Carta de Intención
Carta de Intención
![]() Carta de Recomendación
Carta de Recomendación
TESTIMONIOS

Cynthia Rojo Torres
Titulada del Magíster en Biotecnología (2023)
"Mi experiencia cursando el Magíster en Biotecnología en la Universidad Arturo Prat fue extraordinariamente enriquecedora a nivel profesional. Este programa se destaca por su variada oferta de áreas de estudio, permitiéndome explorar diversas líneas de investigación. Esta amplitud no solo fortaleció y amplió mis conocimientos previos obtenidos en mis carreras de Técnico en Nivel Superior en Análisis Químico e Ingeniería en Biotecnología en la misma universidad, sino que también potenció mi desarrollo profesional en el ámbito biotecnológico. La dedicación y el compromiso de la Universidad Arturo Prat con la excelencia académica fueron fundamentales para alcanzar mis objetivos y seguir avanzando en mi carrera."
BENEFICIOS
Debes llenar la ficha desde AQUÍ
DOCUMENTOS A PRESENTAR POR ESTUDIANTES NUEVOS.
DOCUMENTOS OBLIGATORIOS:
- CURRICULUM VITAE.
- COPIA DE CEDULA DE IDENTIDAD, DOCUMENTO NACIONAL DE IDENTIDAD, PASAPORTE O EQUIVALENTES.
- COPIA DEL GRADO ACADÉMICO DE LICENCIADO/A, TÍTULO PROFESIONAL O EQUIVALENTE.
- CERTIFICADO DE RANKING DE EGRESO DE PREGRADO O EQUIVALENTE.
- CERTIFICADO DE CONCENTRACIÓN DE NOTAS CON PROMEDIO FINAL DE LICENCIATURA, TÍTULO PROFESIONAL O EQUIVALENTE.
- CARTA DE ACEPTACIÓN A PROGRAMA DE MAGISTER.
- DOS CARTAS DE RECOMENDACIÓN CONFIDENCIAL.
DOCUMENTOS OPCIONALES:
- CALIFICACIONES OBTENIDAS HASTA LA FECHA (quienes postulan ya estudiando en el programa de postgrado).
- COPIA DE DIPLOMA O CERTIFICADO DE OTROS PROGRAMAS DE POSTGRADO REALIZADOS.
- CERTIFICADO DE CONCENTRACIÓN DE NOTAS DE OTROS PROGRAMAS REALIZADOS.
DOCUMENTOS PARA PUNTAJE ADICIONAL:
- CERTIFICADO QUE ACREDITE PERTENENCE A UNA ETNIA EMITIDO POR ÓRGANO COMPETENTE.
- CERTIFICADO DE DISCAPACIDAD EMITIDO POR ÓRGANO COMPETENTE.
- CERTIFICADO DE RESIDENCIA.
ESTUDIANTES REGULARES/ANTIGUOS SOLO ENVIAR FORMULARIO.
reglamento..















